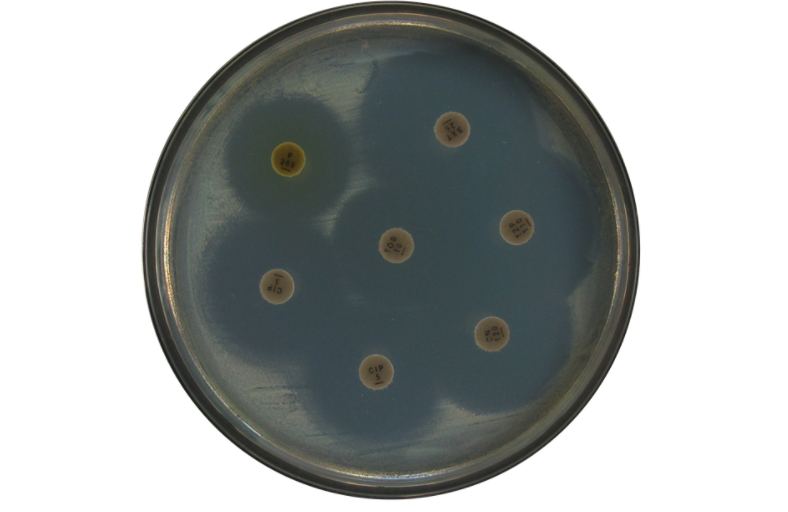
image.png

MIC最低抑菌濃度檢測方法
MIC定義:能夠抑制細菌生長、繁殖的最低藥物濃度即最小抑菌濃度。咨詢電話:13816144967(微信同號)
MIC檢測方法,常用的檢測方法一般有三種:微量肉湯稀釋法(96孔板法)、瓊脂稀釋法、常量肉湯稀釋法。
一、微量肉湯稀釋法(96孔板法):主要適用于需氧菌及局部兼性厭氧菌。
原理:將倍比稀釋后不同濃度的抗(抑)菌產品溶液分別加到滅菌的96孔聚苯乙烯板中,第1至第11孔加樣液,每孔10μl,第12孔不加樣作為生長對照,冰凍干燥后密封,-20℃以下保存備用。接種物制備將用生長法或直接菌懸液法制備的濃度相當于0.5麥氏比濁標準的菌懸液,經 MH肉湯1:1000稀釋后,向每孔中加100μl,密封后置35℃普通空氣孵箱中,孵育16~20h判斷結果。
優點:能夠更準確的得到細菌對某種抗(抑)菌產品的MIC值。
缺點:操作較為繁瑣。
二、瓊脂稀釋法;適用于不溶性抗(抑)菌產品。
原理:是將不同劑量的抗(抑)菌產品,加入融化并冷至50℃左右的定量MH瓊脂中,制成含不同遞減濃度抗(抑)菌產品的平板,接種受試菌,孵育后觀察細菌生長情況,以抑制細菌生長的瓊脂平板所含最低藥物濃度為MIC。
優點:可在一個平板上同時作多株菌MIC測定,結果可靠,易發現污染菌。
缺點:制備含抗(抑)菌產品的瓊脂平板費時費力。
三、常量肉湯稀釋法:適用于可溶性抗(抑)菌產品。
原理:本試驗將不同濃度的抑菌劑混合溶解于營養肉湯培養基中,然后接種細菌,通過細菌的生長與否,確定抗(抑)菌產品抑制受試菌生長的最低濃度,即最小抑菌濃度。
優點:通過觀察培養基是否渾濁較直觀判定測試樣品對特定菌種的MIC值。
缺點:只能測試水溶性好且清澈透明的樣品,而且肉眼觀察有一定的誤差。咨詢電話:13816144967(微信同號)




